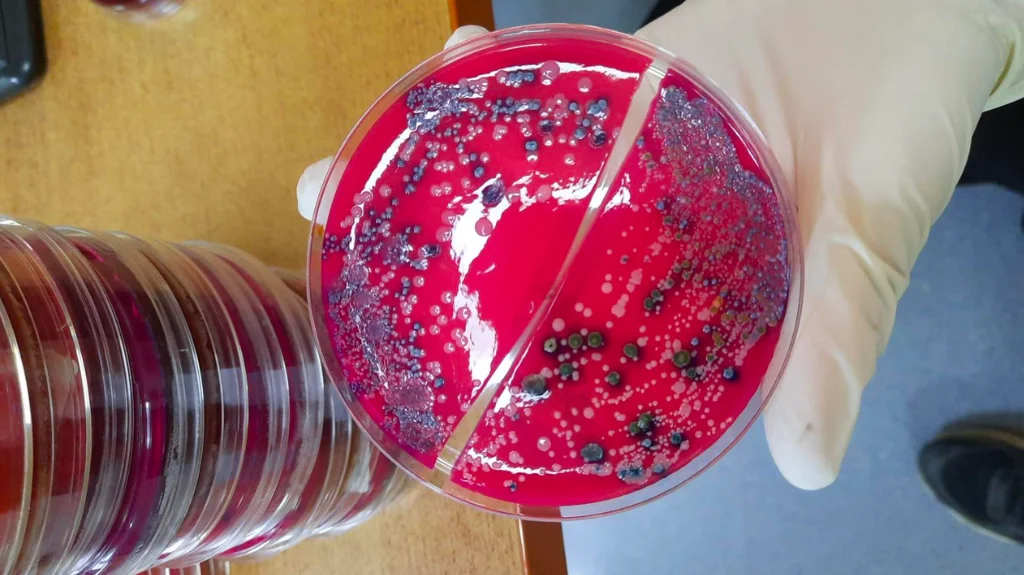
Mikrobiyolojik Besiyerler Hakkında
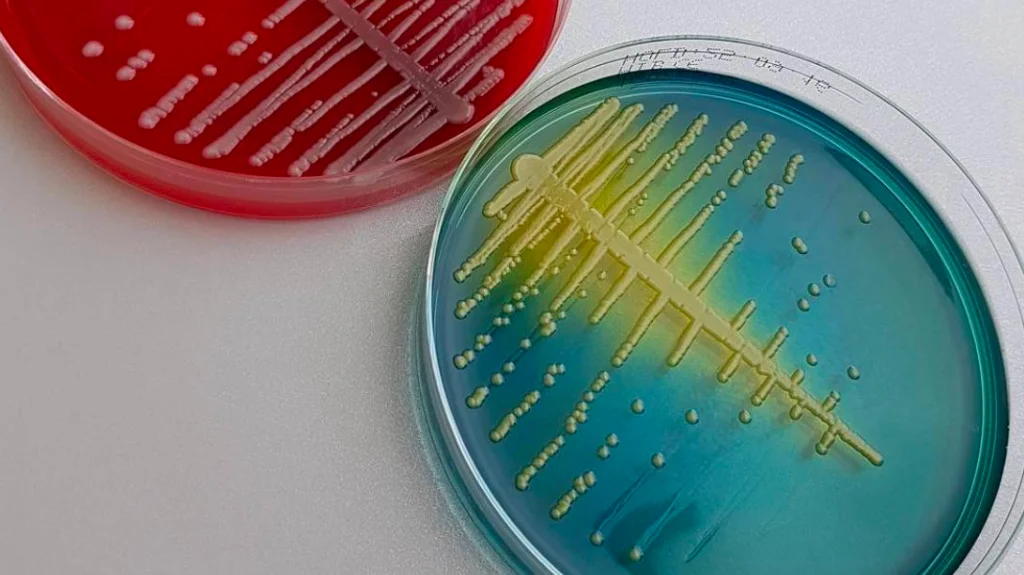
Boyama Setleri : Bilimsel Gelişmeler ve Uygulamalar
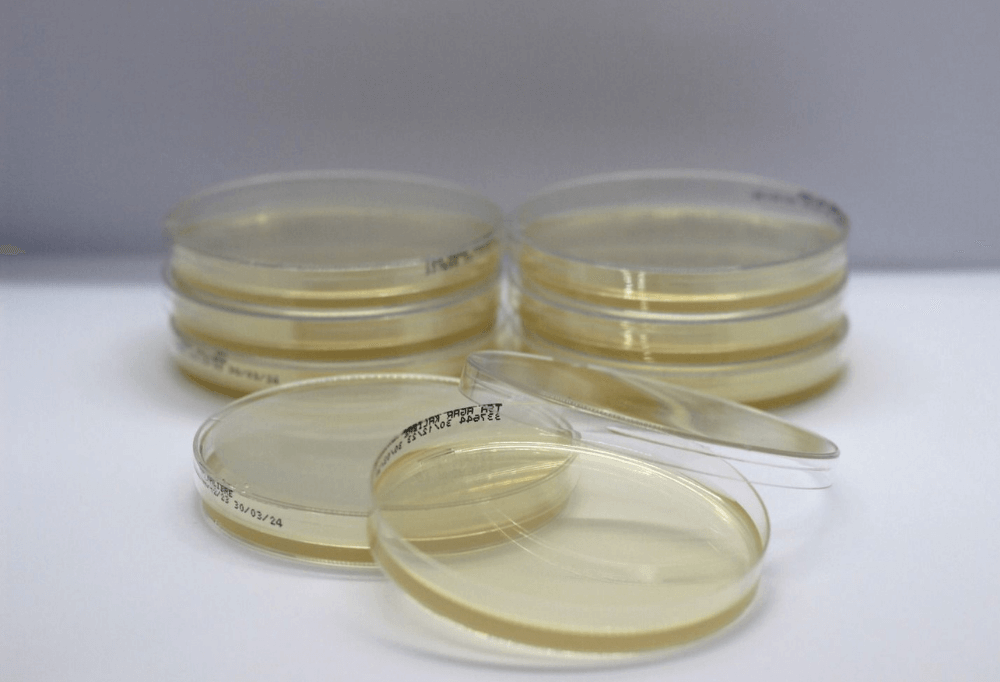
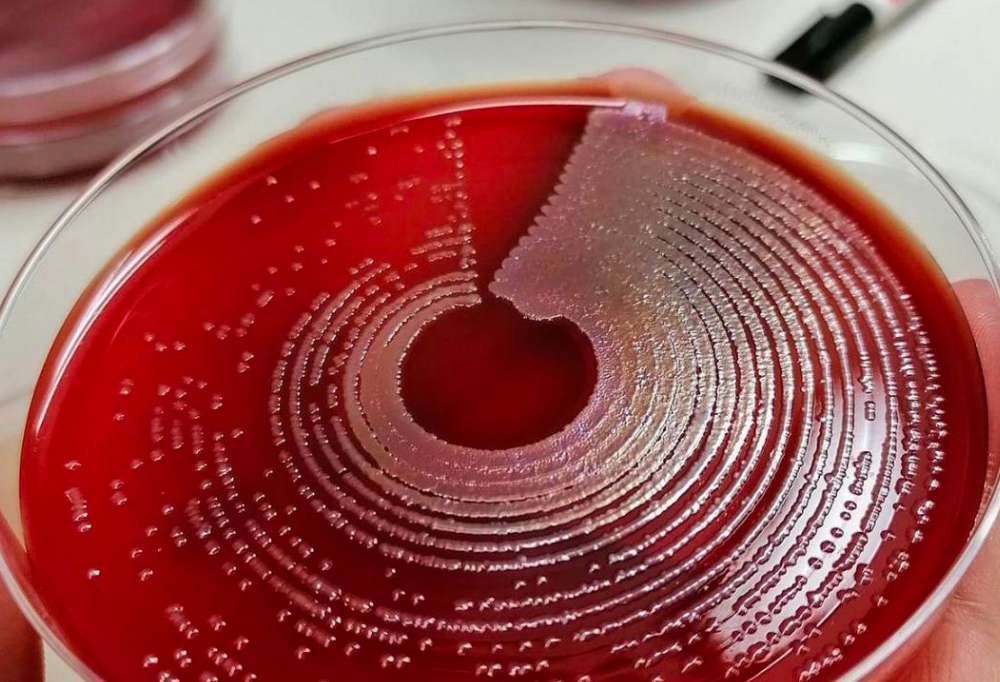
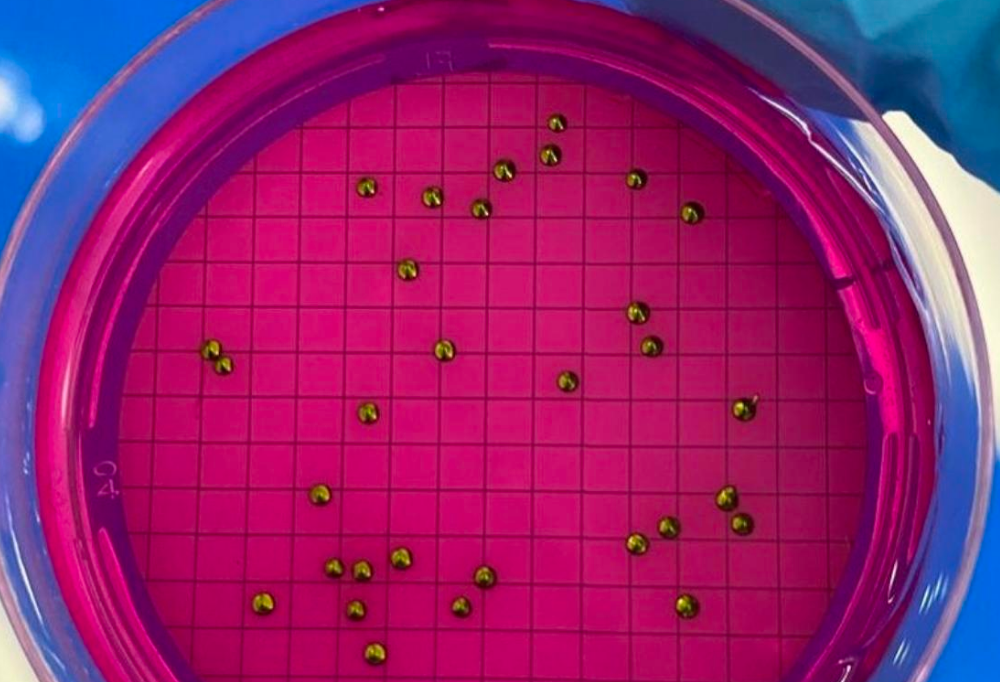
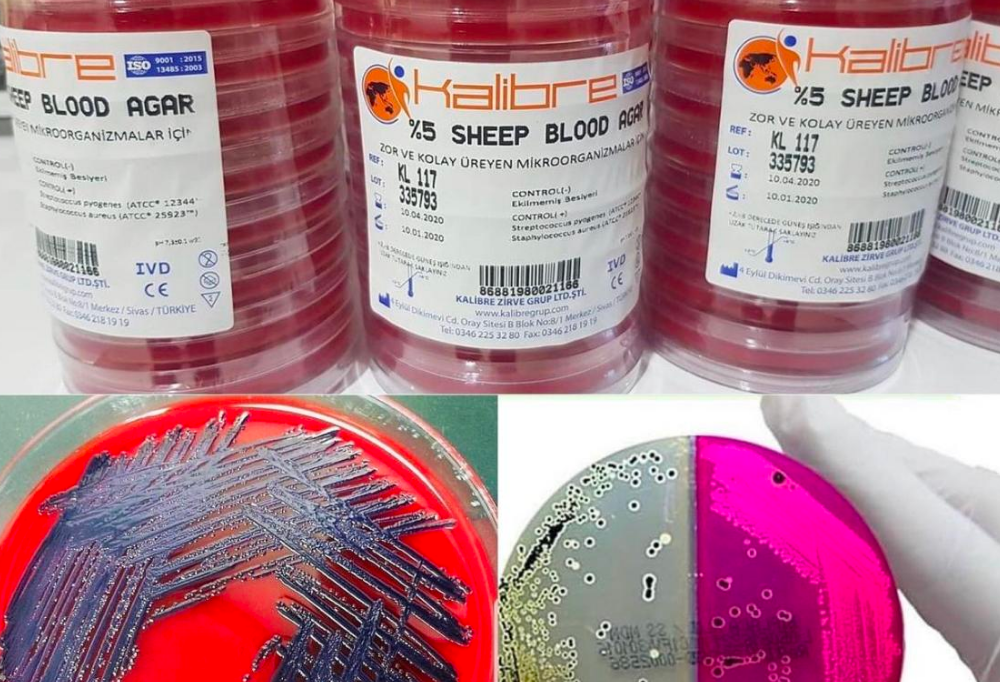

Sağlık sektöründe faaliyet gösteren ve sağlık hizmetlerini düzenleme, yönlendirme veya sağlık alanındaki araştırmaları yürütme amacı güden kurumlarla birlikte çalışmaktayız.
Kalibre Grup mikrobiyolojik teşhis için yüksek kaliteli kullanıma hazır kültür ortamları üretmektedir. Laboratuvar hizmetlerinizin kalitesini güvence altına almak için sistem ortağınız olmaya adanmış bulunmaktayız. Sistem ortağınız olarak, size sadece güvenilir bir şekilde kullanıma hazır kültür ortamlarınızı sağlamakla kalmıyor, aynı zamanda iç kalite kontrol sisteminize destek sunuyor ve kalite kontrol maliyetinizi sürdürülebilir bir şekilde azaltmanıza yardımcı oluyoruz. Laboratuarınızda sorunsuz süreçleri sağlamak için her zaman gerekli olan tüm malzemelerin temin edilmesini sağlıyoruz. Mikrobiyolojik laboratuvarda 20 yıllık deneyime sahibiz ve bu nedenle müşterilerimizin gereksinimlerini ve günlük zorluklarını içtenlikle bilmekteyiz. İhtiyaçlarınızı anlıyor ve teşhis kültür ortamları için iyi bir tedarikçinin işiniz için ne kadar önemli olduğunu biliyoruz. Bu nedenle, kullanıma hazır kültür ortamlarınızı daha rahat bir şekilde tedarik etmenize ve başarınıza katkıda bulunmamıza olanak tanıyabiliriz.
- Mikrobiyoloji
- Moleküler Biyoloji
- Mikroskopi
- COVID-19